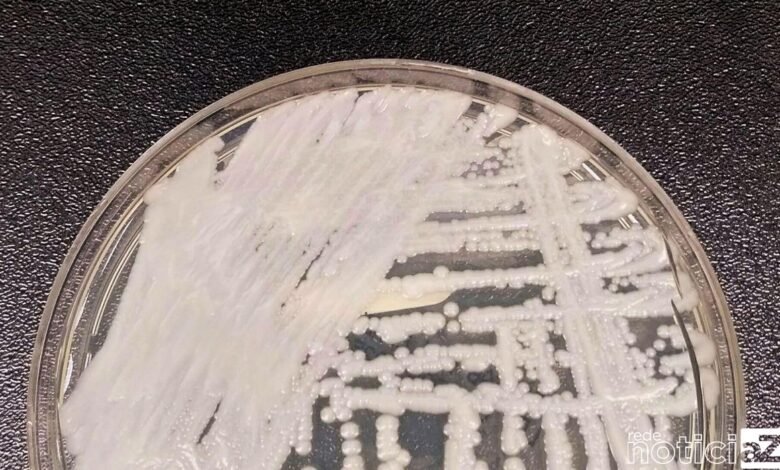

Fiocruz e Pasteur vão pesquisar sobre danos dos fungos no ser humano
Unidade do instituto francês será instalada no Paraná
A Fundação Oswaldo Cruz (Fiocruz) e o Instituto Pasteur firmaram parceria para pesquisar, pelos próximos cinco anos, como os fungos causam danos ao ser humano e ajudar pessoas que sofrem com doenças fúngicas.

Os estudos serão realizados por uma unidade internacional do Instituto Pasteur, que ficará localizada no Instituto Carlos Chagas do Paraná. O contrato foi assinado em abril deste ano. As instituições terão ainda o apoio da Universidade de Birmingham, na Inglaterra.
Descoberta brasileira
A implantação da unidade do instituto francês no Brasil surgiu após uma descoberta de pesquisadores brasileiros. Há 15 anos um grupo brasileiro identificou, pela primeira vez, a existência de vesículas extracelulares em fungos.
Posteriormente, descobriu-se que as vesículas são usadas como veículos pelos fungos para atacar e causar danos ao organismo humano.
De acordo com o coordenador da Fiocruz Paraná, Marcio Rodrigues, pesquisas posteriores, desenvolvidas por franceses e ingleses, indicam que as vesículas podem ser usadas para estudos sobre vacinas e resistência a medicamentos antifúngicos.
“Nosso modelo principal de estudo é o fungo Cryptococcus, que causa infecções cerebrais muito letais. Mas essas vesículas parecem ser produzidas por todos os fungos estudados até agora. Trata-se de uma característica geral e essencial para a biologia de fungos”, explica o pesquisador em publicação da Fiocruz.
Fiocruz e Pasteur trabalham no tema desde 2018. Com a unidade internacional, está previsto intercâmbio de pesquisadores e equipamentos. Haverá reuniões no Instituto Pasteur, em Paris, ainda neste mês e na Universidade de Birmingham, em novembro.
Leia mais
Nova subvariante da Ômicron é detectada no Brasil e Fiocruz diz que ela é mais contagiosa



